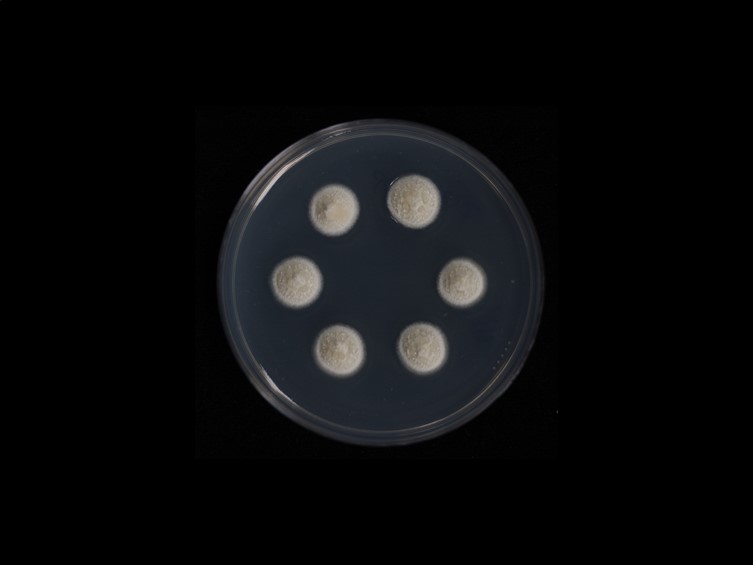

Holotype:
THAILAND, Surat Thani Province, Khao Sok National Park, 28 Nov. 2012, A. Khonsanit, D. Thanakitpipattana, K. Tasanathai, P. Srikitikulchai, W. Noisripoom, holotype BBH 33037, ex-type living culture BCC 60891.
Habitat:
On dicotyledonous leaves.
Host:
Scale insects (Coccidae).
Description:
 Anamorphic stromata flat to umbonate, subglobose, 1-5 mm in diam, 1-1.5 mm in thick, white, brilliant yellow conidial masses.
Anamorphic stromata flat to umbonate, subglobose, 1-5 mm in diam, 1-1.5 mm in thick, white, brilliant yellow conidial masses.  Conidiomata aggregated on the center of stromata, few conidiomata per stromata (2-5), U-shaped, rim around the orifice thick, narrow widely open orifices, 280-420 × 120-300 μm.
Conidiomata aggregated on the center of stromata, few conidiomata per stromata (2-5), U-shaped, rim around the orifice thick, narrow widely open orifices, 280-420 × 120-300 μm.  Phialides hyaline, cylindrical, 11-15 × 1 μm.
Phialides hyaline, cylindrical, 11-15 × 1 μm.  Conidia hyaline, fusiform, 7-10 × 1-2 μm. Paraphyses present, hyaline, filiform, up to 57 μm long, 1-1.5 μm wide.
Conidia hyaline, fusiform, 7-10 × 1-2 μm. Paraphyses present, hyaline, filiform, up to 57 μm long, 1-1.5 μm wide.  Teleomorphic stromata flat to umbonate, subglobose, 3-3.5 mm in diam, white.
Teleomorphic stromata flat to umbonate, subglobose, 3-3.5 mm in diam, white.  Perithecia scattered, semi-embedded, occasionally developing singly in stromata, numerous perithecia per stroma (≥5), obpyriform, 260-420 × 110-230 μm. Ostioles vivid yellow.
Perithecia scattered, semi-embedded, occasionally developing singly in stromata, numerous perithecia per stroma (≥5), obpyriform, 260-420 × 110-230 μm. Ostioles vivid yellow.  Asci hyaline, cylindrical, 130-185 × 5-7 μm. Asci-caps hemispherical, 4-5 × 5-7 μm.
Asci hyaline, cylindrical, 130-185 × 5-7 μm. Asci-caps hemispherical, 4-5 × 5-7 μm.  Ascospores hyaline, disarticulating into part-spores, cylindrical with rounded ends, 5-10.5 × 1-2 μm. The teleomorph and anamorph are present in the same stroma.
Ascospores hyaline, disarticulating into part-spores, cylindrical with rounded ends, 5-10.5 × 1-2 μm. The teleomorph and anamorph are present in the same stroma.
Culture characteristics:
Colonies on PDA compact, convex to pulvinate, flat at the margins, attaining a diam of 8–9 mm in 2 wk, white, yellowish white conidial masses.
Colonies on PDA compact, convex to pulvinate, flat at the margins, attaining a diam of 8–9 mm in 2 wk, white, yellowish white conidial masses.
Reference:
Khonsanit A, Noisripoom W, Mongkolsamrit S, et al. (2021). Five new species of Moelleriella infecting scale insects (Coccidae) in Thailand. Mycological Progress 20: 847–867.
DOI: https://doi.org/10.1007/s11557-021-01709-5Species |
Strain |
Compound |
Pubchem CID |
Biological activity |
Reference |
|---|
|
Strain |
LSU | RPB1 | TEF1 |
|---|---|---|---|
| BCC 58543 | MT659366 | MT672274 | MT672283 |
| BCC 58544 | MT659367 | MT843898 | MT672284 |
| BCC 60891 | MW080318 | MW085942 | MT672282 |